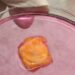
مركز أبوظبي للخلايا الجذعية يطلق علاجا مبتكرا للسرطان

قال الرئيس الأميركي، دونالد ترامب، الأحد إن الجيش الأميركي قد ينشر قوات في نيجيريا أو ينفذ ضربات جوية فيها.
ونقلت وكالة رويترز عن ترامب قوله، من على متن الطائرة الرئاسية لدى سؤاله بشأن إمكانية نشر قوات برية في نيجيريا أو تنفيذ ضربات جوية هناك: “قد يكون ذلك. أقصد ربما أشياء أخرى أيضا. أتصور الكثير من الأمور”.
وتابع ترامب: “إنهم يقتلون أعدادا قياسية من المسيحيين في نيجيريا.. إنهم يقتلون المسيحيين بأعداد كبيرة جدا..لن نسمح بحدوث ذلك”.
في المقابل، أكدت نيجيريا، الأحد، أنها سترحب بالمساعدة الأميركية في مكافحة المسلحين شريطة احترام سلامة أراضيها، وذلك ردا على تهديدات ترامب بالتدخل العسكري.
وكان ترامب قد صرح، السبت، بأنه طلب من وزارة الدفاع الاستعداد لعمل عسكري “سريع” محتمل في نيجيريا إذا لم تتخذ أكبر دولة في أفريقيا من حيث عدد السكان إجراءات حاسمة لوقف قتل المسيحيين.
وقال دانيال بوالا، مستشار الرئيس النيجيري بولا تينوبو، لرويترز “نرحب بالمساعدة الأميركية طالما أنها تحترم سلامة أراضينا”.
وأضاف: “أنا متأكد من أنه بحلول الوقت الذي يجتمع فيه هذان الزعيمان ويجلسان فيه، ستكون هناك نتائج أفضل في عزمنا المشترك على مكافحة الإرهاب”.
وقال بوالا إن نيجيريا “لا تمارس التمييز ضد أي قبيلة أو دين في جهود مكافحة انعدام الأمن.. لا توجد إبادة جماعية للمسيحيين”.